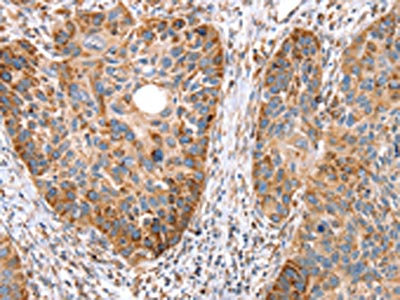

SSBP1 Antibody
-
中文名稱:SSBP1兔多克隆抗體
-
貨號:CSB-PA044833
-
規格:¥1100
-
圖片:
-
The image on the left is immunohistochemistry of paraffin-embedded Human thyroid cancer tissue using CSB-PA044833(SSBP1 Antibody) at dilution 1/20, on the right is treated with fusion protein. (Original magnification: ×200)
-
The image on the left is immunohistochemistry of paraffin-embedded Human esophagus cancer tissue using CSB-PA044833(SSBP1 Antibody) at dilution 1/20, on the right is treated with fusion protein. (Original magnification: ×200)
-
-
其他:
產品詳情
-
Uniprot No.:
-
基因名:
-
別名:mitochondrial antibody; Mt SSB antibody; Mt-SSB antibody; MtSSB antibody; PWP1 interacting protein 17 antibody; PWP1-interacting protein 17 antibody; SENSOR OF SINGLE-STRANDED DNA COMPLEX antibody; Single stranded DNA binding protein 1 antibody; Single stranded DNA binding protein antibody; Single stranded DNA binding protein mitochondrial antibody; Single-stranded DNA-binding protein antibody; SOSS B1 antibody; SOSS COMPLEX, SUBUNIT B1 antibody; SSBP 1 antibody; SSBP antibody; SSBP_HUMAN antibody; SSBP1 antibody
-
宿主:Rabbit
-
反應種屬:Human,Mouse,Rat
-
免疫原:Fusion protein of Human SSBP1
-
免疫原種屬:Homo sapiens (Human)
-
標記方式:Non-conjugated
-
抗體亞型:IgG
-
純化方式:Antigen affinity purification
-
濃度:It differs from different batches. Please contact us to confirm it.
-
保存緩沖液:-20°C, pH7.4 PBS, 0.05% NaN3, 40% Glycerol
-
產品提供形式:Liquid
-
應用范圍:ELISA,IHC
-
推薦稀釋比:
Application Recommended Dilution ELISA 1:2000-1:5000 IHC 1:25-1:100 -
Protocols:
-
儲存條件:Upon receipt, store at -20°C or -80°C. Avoid repeated freeze.
-
貨期:Basically, we can dispatch the products out in 1-3 working days after receiving your orders. Delivery time maybe differs from different purchasing way or location, please kindly consult your local distributors for specific delivery time.
-
用途:For Research Use Only. Not for use in diagnostic or therapeutic procedures.
相關產品
靶點詳情
-
功能:Binds preferentially and cooperatively to pyrimidine rich single-stranded DNA (ss-DNA). In vitro, required to maintain the copy number of mitochondrial DNA (mtDNA) and plays a crucial role during mtDNA replication by stimulating the activity of the replisome components POLG and TWNK at the replication fork. Promotes the activity of the gamma complex polymerase POLG, largely by organizing the template DNA and eliminating secondary structures to favor ss-DNA conformations that facilitate POLG activity. In addition it is able to promote the 5'-3' unwinding activity of the mtDNA helicase TWNK. May also function in mtDNA repair.
-
基因功能參考文獻:
- This study identified SSBP1 as a putative N6-methyldeoxyadenosine binding protein. PMID: 30412255
- NEIL1 and homotetrameric mtSSB form a larger ternary complex in presence of DNA, however, the tetrameric form of mtSSB gets disrupted by NEIL1 in the absence of DNA as revealed by the formation of a smaller NEIL1-mtSSBmonomer complex. PMID: 29522991
- These results indicated that SSDBP1 may induce cell chemoresistance of cisplatin through promoting DNA repair, resistance-related gene expression, cell proliferation, and inhibiting apoptosis. PMID: 28210897
- Data show that single-stranded DNA binding protein 1 (hSSB1/NABP2/OBFC2B) forms a tetramer and is stabilized by two cysteines (C81 and C99) as well as a subset of charged and hydrophobic residues. PMID: 28609781
- DNA synthesis determines the binding mode of the human mtSSB. PMID: 28486639
- The data presented in this study suggests that while SSBP1 has predominantly been considered in a DNA repair context, it is likely to have roles in many other cellular processes. In particular, the identification of numerous proteins with roles in mRNA metabolism, transcriptional transactions and ribosomal processes, may suggest these as important areas of SSBP1 function. PMID: 27938330
- Data suggest that human mitochondrial SSB shares many physicochemical properties with E coli SSB and that the differences may be explained by the lack of an acidic, disordered C-terminal tail in human mitochondrial SSB protein. (SSB = single-stranded DNA-binding protein) PMID: 28615444
- Data suggest that human mitochondrial SSB and E coli SSB both protect and expose single-stranded DNA; implications from these studies toward understanding DNA replication and DNA repair abound. (SSB = single-stranded DNA-binding protein) [EDITORIAL] PMID: 28778884
- hSSB1 is directly phosphorylated by DNA-PK at serine residue 134. While this modification is largely suppressed in undamaged cells by PPP-family protein phosphatases, S134 phosphorylation is enhanced following the disruption of replication forks and promotes cellular survival. PMID: 28448822
- The stimulatory effect of mtSSB on Pol gamma on these ssDNA templates is not species-specific. PMID: 26446790
- This study determined that hSSB1 acetylation at K94 mediated by the acetyltransferase p300 and the deacetylases SIRT4 and HDAC10 impaired its ubiquitin-mediated degradation by proteasomes. PMID: 26170237
- SSBP1 protects cells from proteotoxic stresses by potentiating stress-induced HSF1 transcriptional activity PMID: 25762445
- Fbxl5 interacts with and targets hSSB1 for ubiquitination and degradation, which could be prevented by ATM-mediated hSSB1 T117 phosphorylation. PMID: 25249620
- In response to the DNA damage response, INTS3-hSSB1-INTS6 complex relocates to the DNA damage sites. PMID: 23986477
- Results indicate that hSSB1 may regulate DNA damage checkpoints by positively modulating p53 and its downstream target p21. PMID: 23184057
- mtSSB potentially prevents formation of DNA breaks in ssDNA, ensuring that base removal primarily occurs in dsDNA. PMID: 23290262
- Local enrichment of UNG1 at DNA-bound mtSSB may furthermore facilitate rapid access to- and processing of the damage once the dsDNA conformation is restored. PMID: 22153281
- mtSSB uses distinct structural elements to interact functionally with its mtDNA replisome partners and to promote proper mtDNA replication in animal cells PMID: 21953457
- hSSB1 may positively modulate p21 to regulate cell cycle progression and DNA damage response, implicating hSSB1 as a novel, promising therapeutic target for cancers such as hepatocellular carcinoma PMID: 21242961
- Results describe the role of mitochondrial single-stranded DNA binding protein in the maintenance of mitochondrial DNA in cultured human cells. PMID: 20434493
- Data show that mtSSB bound both CKS1 and CKS2 and underwent CDK-dependent phosphorylation. PMID: 19786724
- SSDP1 gene encodes a protein with a conserved N-terminal FORWARD domain;The SSDP1 mRNA transcripts are distributed ubiquitously in adult human and mouse tissues. PMID: 12479417
- PDIP38 is located in the mitochondrial matrix. TFAM and mitochondrial single-stranded DNA binding protein (mtSSB) are co-immunoprecipitated with PDIP38 PMID: 16428295
- Zta interaction with mtSSB serves the dual function of facilitating viral and blocking mitochondrial DNA replication. PMID: 18305033
- Identification of human mitochondrial SSB (HmtSSB) as a novel protein-binding partner of tumour suppressor p53, in mitochondria. PMID: 19066201
- hSSB1 and hSSB2 form two separate complexes with similar structures, and both complexes participate in DNA damage response. PMID: 19605351
- following DNA damage, SSB1 and Integrator3 relocate to the DNA damage sites and regulate the accumulation of TopBP1 and BRCA1 there PMID: 19759019
顯示更多
收起更多
-
亞細胞定位:Mitochondrion. Mitochondrion matrix, mitochondrion nucleoid.
-
組織特異性:Expressed in retinal ganglion cells, photoreceptors, pigmented epithelium and fibroblasts (at protein level).
-
數據庫鏈接:
Most popular with customers
-
-
YWHAB Recombinant Monoclonal Antibody
Applications: ELISA, WB, IHC, IF, FC
Species Reactivity: Human, Mouse, Rat
-
-
-
-
-
-